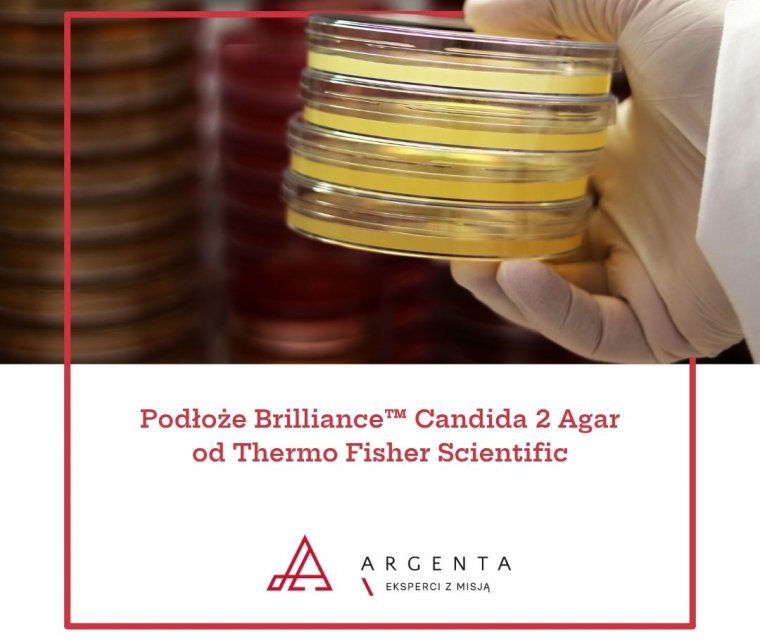

2026
Podłoże Brilliance™ Candida 2 Agar od Thermo Fisher Scientific
W ofercie także bezpośrednia identyfikacja Candida auris
Szanowni Państwo,
oferta Thermo Fisher Scientific została powiększona o podłoże chromogenne Brilliance™ Candida 2 Agar do wykrywania oraz różnicowania najbardziej znaczących klinicznie gatunków Candida.
Zapraszamy do kontaktu w sprawie oferty > Przejdź do formularza
Podłoże Brilliance™ Candida 2 Agar – w tym bezpośrednia identyfikacja Candida auris!
Nowe podłoże chromogenne Brilliance Candida 2 Agar (nr kat. PO5334A) umożliwia szybkie i precyzyjne wykrywanie oraz różnicowanie najbardziej znaczących klinicznie gatunków Candida – w tym Candida auris bez konieczności dodatkowego potwierdzania.
Najważniejsze cechy:
· Wykrywanie i różnicowanie 7 kluczowych gatunków Candida: C. albicans, C. tropicalis, C. krusei, C. glabrata, C. parapsilosis, C. lusitaniae oraz Candida auris.
· Bezpośrednia identyfikacja C. auris – oszczędność czasu i zwiększona pewność diagnostyczna.
· Inkubacja <48 h w 36°C.
· Przechowywanie w temperaturze pokojowej do 5 dni.
· Jasne, łatwe do interpretacji kolory kolonii.
· Wysoka czułość i specyficzność podłoża.
· Możliwość posiewu z szerokiego zakresu materiałów klinicznych.
Zapraszamy do kontaktu w przypadku pytań o nowe produkty!